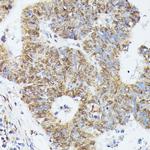
KID Antibody in Immunohistochemistry (Paraffin) (IHC (P))

Search
Invitrogen
KID Polyclonal Antibody
{{$productOrderCtrl.translations['antibody.pdp.commerceCard.promotion.promotions']}}
{{$productOrderCtrl.translations['antibody.pdp.commerceCard.promotion.viewpromo']}}
{{$productOrderCtrl.translations['antibody.pdp.commerceCard.promotion.promocode']}}: {{promo.promoCode}} {{promo.promoTitle}} {{promo.promoDescription}}. {{$productOrderCtrl.translations['antibody.pdp.commerceCard.promotion.learnmore']}}
图: 1 / 4
KID Antibody (PA5-90348) in IHC (P)

Please note: We are reviewing Western blot images included in the antibody testing data in our catalog, including those provided by third parties. Unless expressly labeled or annotated as “raw-unedited”, Western blot images included in the antibody testing data in our catalog may have been edited, optimized or otherwise adjusted for presentation.
产品信息
PA5-90348
种属反应
宿主/亚型
分类
类型
抗原
偶联物
形式
浓度
规格
纯化类型
保存液
内含物
保存条件
运输条件
RRID
产品详细信息
Immunogen sequence: QGAPLLSTPK RERMVLMKTV EEKDLEIERL KTKQKELEAK MLAQKAEEKE NHCPTMLRPL SHRTVTGAKP LKKAVVMPLQ LIQEQAASPN AEIHILKNKG RKRKLESLDA LEPEEKAEDC WELQISPELL AHGRQKILDL LNEGSARDLR SLQRIGPKKA QLIVGWRELH GPFSQVEDLE RVEGITGKQM ESFLKANILG LAAGQRCGAS; Positive Samples: A431, 293T, U-87MG, A549, HeLa, Jurkat, Mouse testis; Cellular Location: Cytoplasm, Nucleus, cytoskeleton
靶标信息
The protein encoded by this gene is a member of kinesin-like protein family. This family of proteins are microtubule-dependent molecular motors that transport organelles within cells and move chromosomes during cell division. The C-terminal half of this protein has been shown to bind DNA. Studies with the Xenopus homolog suggests its essential role in metaphase chromosome alignment and maintenance.
仅用于科研。不用于诊断过程。未经明确授权不得转售。
篇参考文献 (0)
生物信息学
蛋白别名: kinesin family member 22A; kinesin-like 4; Kinesin-like DNA-binding protein; kinesin-like DNA-binding protein pseudogene; Kinesin-like protein 4; Kinesin-like protein KIF22; origin of plasmid DNA replication-binding protein; oriP binding protein; unnamed protein product
基因别名: A-328A3.2; AU021460; C81217; KID; KIF22; Kif22a; KNSL4; OBP; OBP-1; OBP-2; SEMDJL2
UniProt ID: (Mouse) Q3V300
Entrez Gene ID: (Human) 3835, (Mouse) 110033




